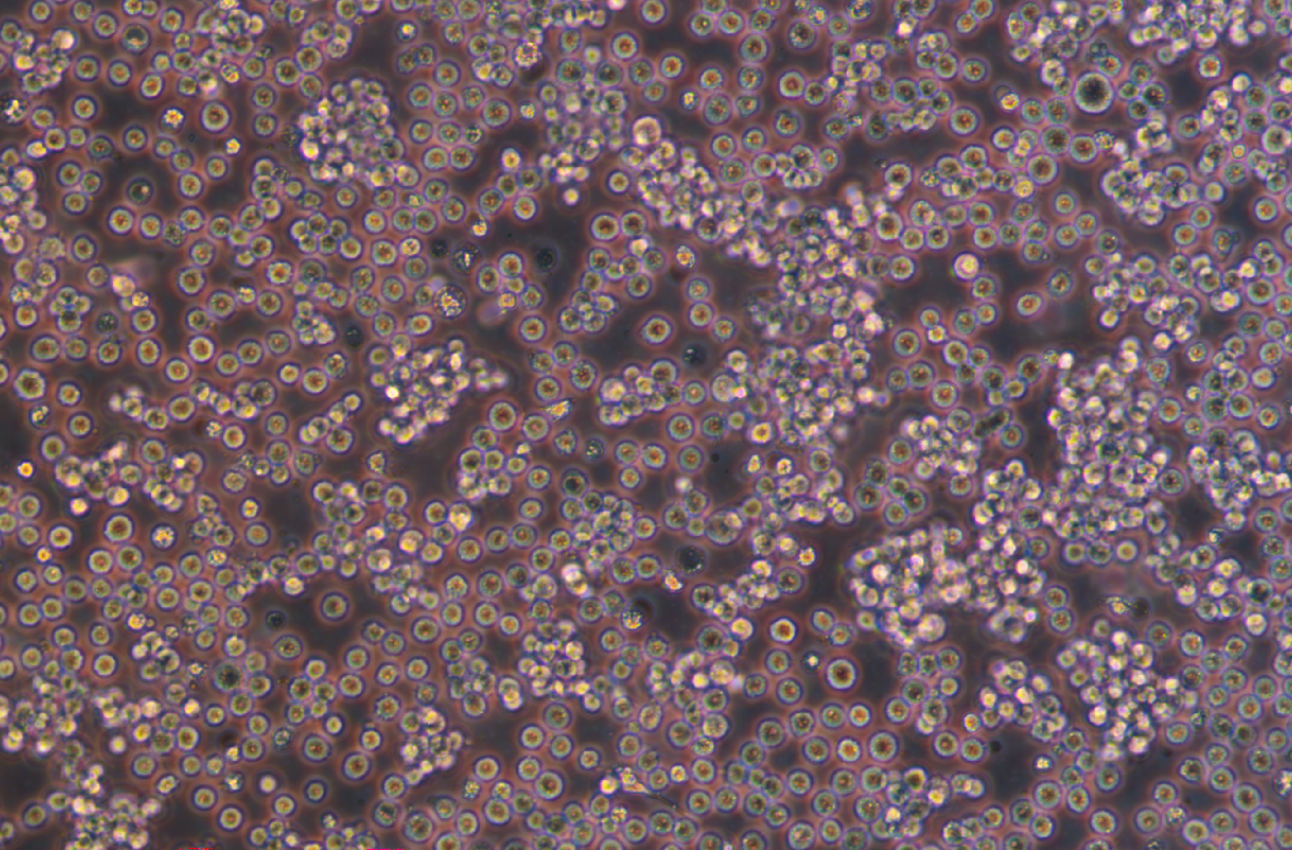
絨猴EBV轉化的白細胞B95-8(種屬鑒定)

|
種屬 |
猴 |
|
別稱 |
B95.8; B 95.8; B 95-8; B-95-8; B958; GM07404; GM07404A; GM07404D |
|
組織來源 |
外周血 |
|
疾病 |
轉化細胞系 |
|
傳代比例/細胞消化 |
1:2傳代 |
|
完全培養基配置 |
RPMI1640養基;10%胎牛血清;1%雙抗 |
|
簡介 |
B95-8細胞源自暴露于人白血球中抽提的EB病毒的絨猴白血球;B95-8細胞是一個連續株,并能釋放高滴度的轉染EB病毒。此細胞提供EB病毒用于建立人的連續淋巴細胞株。 |
|
形態 |
淋巴母細胞樣 |
|
生長特征 |
懸浮生長 |
|
倍增時間 |
~41h |
|
培養條件 |
氣相:空氣,95%;二氧化碳,5%。 溫度:37攝氏度,培養箱濕度為70%-80%。 |
|
凍存條件 |
凍存液:90%FBS,DMSO 10%, 或使用非程序凍存液:官網貨號JY-H040 |
|
保藏機構 |
DSMZ; ACC-100 |
|
備注 |
該細胞為懸浮細胞,請注意離心收集細胞懸液,請勿直接倒掉細胞培養液。 |
|
產品使用 |
僅限于科學研究,不可作為動物或人類疾病的治療產品使用。 |